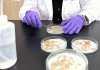

보성군, “볍씨 발아율 꼭 확인하세요” 모내기 전 사전 점검 당부
작성 : 2026년 04월 07일(화) 11:31 가+가-

볍씨 발아율을 확인하고 있다
[톡톡뉴스]보성군은 본격적인 모내기 철을 앞두고 농가를 대상으로 볍씨 발아 상태를 사전에 점검하고 안전 육묘 관리를 철저히 할 것을 당부한다고 밝혔다.
군에 따르면 지난해 등숙기 고온다습한 기상 영향으로 일부 볍씨의 발아 속도가 예년보다 1~2일가량 지연되는 현상이 나타난 것으로 확인됐다. 이에 발아 불균일로 인한 육묘 실패를 예방하기 위한 사전 관리의 중요성이 커지고 있다.
특히, 농가에서 직접 채종·보관한 자가채종 종자는 보급종에 비해 발아율이 낮거나 균일하지 않을 가능성이 높아 파종 전 발아력 검사가 필수적이다. 군은 간이 발아 검사를 통해 발아율 80% 이상 종자를 사용하는 것을 권장하고 있다.
발아율이 80% 미만일 경우 파종량을 늘리거나 종자를 교체하는 등 사전 대응이 가능해 초기 육묘 단계에서 발생할 수 있는 시행착오를 줄일 수 있다.
보성군농업기술센터는 농가의 안정적인 영농을 지원하기 위해 볍씨 발아율 검사를 무료로 실시하고 있다.
검사를 희망하는 농업인은 종자 500g을 봉투에 담아 인적 사항과 품종을 기재한 뒤 농업기술센터 작물환경팀에 제출하면 된다. 검사 결과는 3회 반복 실험을 거쳐 약 7~10일 후 확인할 수 있다.
보성군농업기술센터 김숙희 소장은“안정적인 쌀 생산을 위해서는 종자소독과 볍씨 발아 검정이 벼 재배의 기본 단계”라며, “자가채종 종자는 발아율 확인을 철저히 해 안전 육묘에 힘써주시길 바란다.”라고 말했다. 김미자 기자 기사 더보기
김미자 기자 기사 더보기
군에 따르면 지난해 등숙기 고온다습한 기상 영향으로 일부 볍씨의 발아 속도가 예년보다 1~2일가량 지연되는 현상이 나타난 것으로 확인됐다. 이에 발아 불균일로 인한 육묘 실패를 예방하기 위한 사전 관리의 중요성이 커지고 있다.
특히, 농가에서 직접 채종·보관한 자가채종 종자는 보급종에 비해 발아율이 낮거나 균일하지 않을 가능성이 높아 파종 전 발아력 검사가 필수적이다. 군은 간이 발아 검사를 통해 발아율 80% 이상 종자를 사용하는 것을 권장하고 있다.
발아율이 80% 미만일 경우 파종량을 늘리거나 종자를 교체하는 등 사전 대응이 가능해 초기 육묘 단계에서 발생할 수 있는 시행착오를 줄일 수 있다.
보성군농업기술센터는 농가의 안정적인 영농을 지원하기 위해 볍씨 발아율 검사를 무료로 실시하고 있다.
검사를 희망하는 농업인은 종자 500g을 봉투에 담아 인적 사항과 품종을 기재한 뒤 농업기술센터 작물환경팀에 제출하면 된다. 검사 결과는 3회 반복 실험을 거쳐 약 7~10일 후 확인할 수 있다.
보성군농업기술센터 김숙희 소장은“안정적인 쌀 생산을 위해서는 종자소독과 볍씨 발아 검정이 벼 재배의 기본 단계”라며, “자가채종 종자는 발아율 확인을 철저히 해 안전 육묘에 힘써주시길 바란다.”라고 말했다.
최신뉴스더보기
- 보성군, “볍씨 발아율 꼭 확인하세요” 모내기 전 사전 점검 당부
- [톡톡뉴스]보성군은 본격적인 모내기 철을 앞두고 농가를 대상으로 볍씨 발아 상태를 사전에 점검하고 안전 육묘…

- 보성군, 농산물 가공 창업 교육 ‘순항’ 공유 주방 관심 급증
- [톡톡뉴스]보성군은 7일 농산물 가공 창업 교육이 이론과 실습을 병행한 체계적인 운영으로 농업인들의 높은 호…

- 보성군, 4월 10일부터 농어민 공익수당 70만 원 지급!
- [톡톡뉴스]보성군은 오는 10일부터 5월 31일까지 농어업인의 소득 안정을 지원하고 지역경제 활성화를 도모하…

- 보성군, 2026년 법인지방소득세 집중 신고 기간 운영
- [톡톡뉴스]보성군은 2025년 12월 결산법인을 대상으로 2026년 법인지방소득세(2025년 귀속) 집중 신…

- 보성군, 2026년 청년 DREAM UP 프로젝트 추진
- [톡톡뉴스]보성군은 고향사랑기부제로 조성된 기금 6,000만 원을 활용해 지역 청년의 취업·창업을 지원하는 …

- 보성군, 서울예술단 ‘청사초롱 불 밝혀라’ 공연 협약 체결
- [톡톡뉴스]보성군은 지난 2일 서울예술단(단장 류상록)과 창작가무극 ‘청사초롱 불 밝혀라’의 공연 개최를 위…

- 보성군 조성면-고흥군 대서면, 고향사랑기부제로 2년째 상생 협력
- [톡톡뉴스] 보성군은 지난 2일 조성면이 고흥군 대서면과 고향사랑기부제 상호 기부를 추진하며 지역 간 상…

- 보성군, ‘제13회 보성벚꽃축제’.‘제22회 문덕면민의 날’ 개최
- [톡톡뉴스] 보성군은 4월 3일부터 12일까지 보성군립백민미술관 일원에서 ‘제13회 보성벚꽃축제’와 ‘제…

- 보성군, 카드형 보성사랑상품권 주유소 특별 할인 시행
- [톡톡뉴스] 보성군은 4월 3일부터 6월까지 관내 주유소 이용 시 카드형 보성사랑상품권 할인 혜택을 기존…

- 보성군, ‘따숨 한 끼 식사 배달 지원사업’으로 고독·고립 예방 강화
- [톡톡뉴스]보성군은 고독·고립 위험 가구에 대한 선제 대응과 촘촘한 복지 안전망 구축을 위해 ‘따숨 한 끼 …
Copyright © 2016 뉴스톡톡. All Rights Reserverd.

